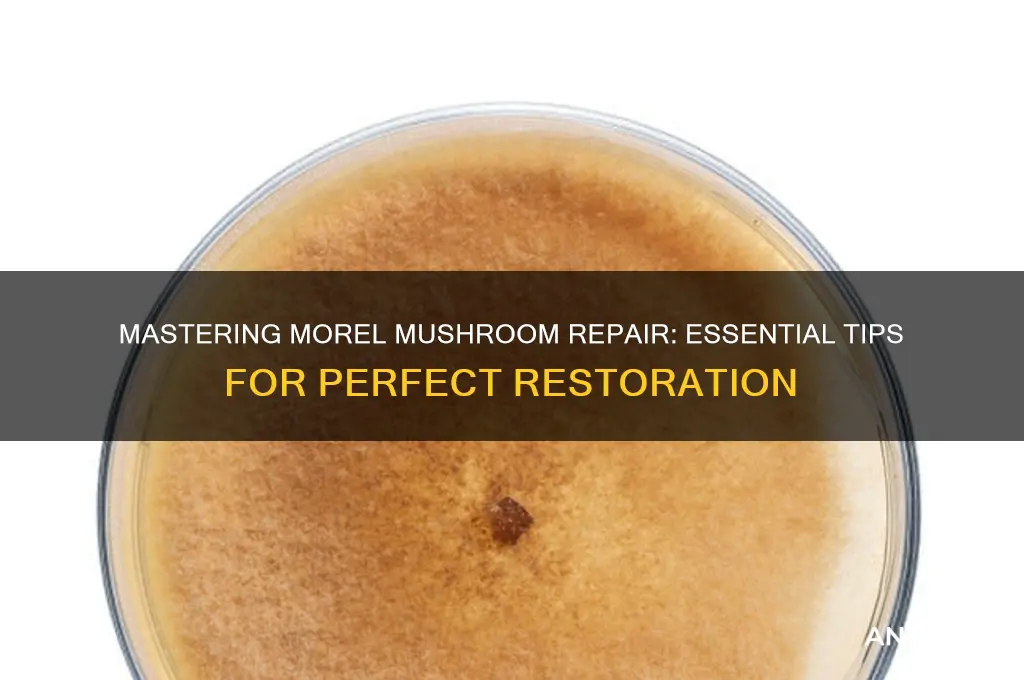
how do you fix morel mushrooms

Morel mushrooms, prized for their unique flavor and texture, require careful handling to preserve their quality. Fixing or preparing morels involves cleaning them thoroughly to remove dirt and debris, as their honeycomb-like structure can trap particles. Start by gently brushing the mushrooms with a soft brush or rinsing them briefly in cold water, ensuring not to soak them, as they can absorb moisture and become soggy. After cleaning, pat them dry with a paper towel or let them air dry. Depending on your recipe, you can then sauté, fry, or incorporate them into dishes like soups, sauces, or pasta, enhancing their earthy taste while maintaining their delicate structure. Proper preparation ensures morels remain a standout ingredient in any culinary creation.
| Characteristics | Values |
|---|---|
| Cleaning Method | Gently brush or rinse with cold water to remove dirt and debris; avoid soaking as morels absorb water |
| Drying (Optional) | Air-dry or use a dehydrator at low heat (135°F/57°C) for preservation; ensures longer shelf life |
| Cooking Methods | Sautéing, frying, or adding to soups/sauces; cook thoroughly to eliminate any potential toxins |
| Flavor Profile | Earthy, nutty, and meaty; enhances dishes with umami flavor |
| Storage (Fresh) | Store in a paper bag in the refrigerator for up to 3 days; avoid plastic bags to prevent moisture buildup |
| Storage (Dried) | Keep in an airtight container in a cool, dark place for up to a year |
| Rehydrating (Dried) | Soak in warm water for 20-30 minutes before use; reserve soaking liquid for added flavor |
| Pairings | Butter, garlic, cream, asparagus, chicken, or pasta; complements rich and savory dishes |
| Safety Tip | Always cook morels thoroughly; raw or undercooked morels can cause digestive issues |
| Seasonality | Spring (April-June) in North America; foraged in wooded areas with deciduous trees |
Explore related products
What You'll Learn
- Soil Preparation: Amend soil with wood ash, lime, or gypsum to achieve pH 7.0
- Tree Selection: Plant or locate near ash, oak, or elm trees for symbiotic growth
- Spores and Inoculation: Use spore slurries or inoculated logs to introduce mycelium
- Moisture Management: Maintain consistent soil moisture; water during dry periods to support growth
- Harvesting Techniques: Gently twist mushrooms at the base to avoid damaging mycelium

Soil Preparation: Amend soil with wood ash, lime, or gypsum to achieve pH 7.0
Morel mushrooms thrive in soil with a neutral pH, ideally around 7.0. Achieving this balance is crucial because it directly influences nutrient availability and microbial activity, both of which are essential for mycelium growth. Soil that is too acidic or alkaline can hinder spore germination and fruiting. To correct pH levels, wood ash, lime, or gypsum are commonly used amendments, each with distinct properties and application methods.
Wood ash, a byproduct of burning hardwood, is rich in potassium and calcium carbonate, which raises soil pH. It’s a natural, cost-effective option but should be applied sparingly—typically 1 to 2 pounds per 100 square feet—as excessive use can lead to nutrient imbalances. Lime, available as calcitic or dolomitic, is another effective pH adjuster. Calcitic lime primarily adds calcium, while dolomitic lime provides both calcium and magnesium. Apply 5 to 10 pounds of lime per 100 square feet for moderately acidic soil, adjusting based on a soil test. Gypsum, or calcium sulfate, is ideal for soils with high salinity or compacted clay, as it improves structure without significantly altering pH. Use 10 to 20 pounds per 100 square feet for best results.
The choice of amendment depends on your soil’s specific needs. For instance, if a soil test reveals low calcium levels, lime is preferable. If salinity is the issue, gypsum is the better choice. Wood ash is best for slightly acidic soil with potassium deficiencies. Always test soil pH before amending, as over-application can cause more harm than good. Incorporate the chosen material into the top 4 to 6 inches of soil, ensuring even distribution.
Timing is critical for soil preparation. Amend the soil in the fall to allow the material to integrate naturally over winter, creating an optimal environment for morel mycelium by spring. Avoid applying amendments during the growing season, as this can shock the soil ecosystem. Pair pH adjustments with organic matter, such as compost or leaf litter, to enhance soil structure and microbial diversity, further supporting morel growth.
In conclusion, achieving a pH of 7.0 through targeted amendments is a foundational step in cultivating morel mushrooms. By selecting the right material, applying it correctly, and timing the process thoughtfully, you create a soil environment where morels can flourish. This precision in soil preparation not only increases the likelihood of a successful harvest but also fosters a sustainable habitat for these elusive fungi.
Magic Mushrooms: Identifying the Psilocybin-Containing Varieties
You may want to see also

Tree Selection: Plant or locate near ash, oak, or elm trees for symbiotic growth
Morel mushrooms thrive in symbiotic relationships with specific tree species, and selecting the right trees is crucial for their growth. Ash, oak, and elm trees are particularly beneficial due to their ability to form mycorrhizal associations with morels. These trees provide essential nutrients and a stable environment, fostering the conditions morels need to flourish. By planting or locating your morel cultivation near these trees, you create a natural ecosystem that supports their development.
When choosing a location, consider the age and health of the trees. Mature ash, oak, or elm trees, typically over 10 years old, are ideal as they have established root systems capable of supporting mycorrhizal fungi. Younger trees may not yet have the capacity to form these symbiotic relationships effectively. Additionally, ensure the trees are healthy and free from diseases or pests, as stressed trees can negatively impact morel growth. If planting new trees, opt for saplings from local nurseries to ensure they are adapted to your region’s climate and soil conditions.
The process of planting morel mushrooms near these trees involves more than just proximity. Prepare the soil by loosening it to a depth of 6–8 inches and incorporating organic matter like compost or well-rotted leaves. This mimics the forest floor environment morels prefer. After planting, maintain consistent moisture levels, as morels require damp but not waterlogged soil. Mulching around the base of the trees with straw or wood chips can help retain moisture and regulate soil temperature, further supporting both tree and mushroom health.
One practical tip is to observe natural morel habitats for inspiration. Morels often appear in areas where ash, oak, or elm trees have experienced disturbances, such as fallen limbs or fire damage. Replicating these conditions by lightly disturbing the soil around the trees or adding wood debris can encourage morel growth. However, avoid over-disturbing the area, as this can disrupt the delicate mycorrhizal network. Patience is key, as it may take 1–2 years for morels to establish and produce fruiting bodies.
In conclusion, tree selection is a foundational step in cultivating morel mushrooms. By strategically planting or locating your efforts near ash, oak, or elm trees, you harness the power of symbiotic relationships to create an optimal growing environment. With careful attention to tree health, soil preparation, and maintenance, you can significantly increase your chances of a successful morel harvest. This approach not only benefits the mushrooms but also contributes to a thriving, balanced ecosystem.
Mastering Mushroom Gills: Sewing Intricate Details
You may want to see also

Spores and Inoculation: Use spore slurries or inoculated logs to introduce mycelium
Morel mushrooms, with their honeycomb caps and elusive nature, are a forager’s dream. But cultivating them reliably? That’s where spore slurries and inoculated logs step in as game-changers. These methods bypass the unpredictability of wild morels by introducing mycelium—the vegetative backbone of fungi—directly into controlled environments. Think of it as planting seeds, but for mushrooms, where the "seed" is a suspension of spores or mycelium-infused wood.
The Spore Slurry Method: Precision in a Jar
Creating a spore slurry is part science, part art. Start by collecting mature morel spores—either from a purchased spore syringe or by carefully capturing them from a fresh mushroom. Mix the spores into a sterile solution of distilled water and a mild sugar source (like dextrose) to feed early mycelial growth. The ratio? Aim for 1-2 cc of spores per liter of solution. This slurry is then introduced to a sterile substrate, such as pasteurized straw or wood chips, in a controlled environment. The key here is sterility; contamination by competing molds or bacteria can derail the process. Once the mycelium colonizes the substrate, it’s transferred to a fruiting chamber with high humidity and cooler temperatures to coax out those prized morels.
Inoculated Logs: Nature Meets Nurture
For a more hands-off approach, inoculated logs are the way to go. Select hardwood logs (ash, elm, or cottonwood work well) cut during the dormant season and drill holes 6-8 inches apart. Using a spore slurry or mycelium plug, fill each hole and seal it with wax to retain moisture. Stack the logs in a shaded, moist area, and let time do its work. Mycelium will slowly colonize the log over 6-12 months, eventually producing morels in spring. This method mimics morels’ natural habitat, though it requires patience—logs may fruit for several years, making it a long-term investment.
Comparing the Two: Which Fits Your Goals?
Spore slurries offer faster results and greater control, ideal for small-scale growers or those experimenting with strains. Inoculated logs, however, align with permaculture principles, blending seamlessly into outdoor spaces and requiring minimal intervention. The trade-off? Slurries demand precision and sterility, while logs test your patience. For beginners, starting with inoculated logs provides a forgiving entry point, whereas slurries suit those ready to dive into the intricacies of mycology.
Practical Tips for Success
Whichever method you choose, consistency is key. Monitor humidity levels—morels thrive at 80-90% humidity during fruiting. For spore slurries, invest in a pressure cooker to sterilize substrates and tools. With logs, ensure they remain damp but not waterlogged; a light misting every few days suffices. And remember: mycelium is resilient but not invincible. Keep an eye out for green molds or unusual odors, signs of contamination that may require starting over.
By harnessing spores and inoculation, you’re not just growing morels—you’re cultivating a deeper understanding of fungi’s life cycle. Whether through a jar of slurry or a stack of logs, this approach transforms the elusive morel from a wild find into a cultivated treasure.
Preserving the Perfect Puffball: Techniques for Longevity
You may want to see also
Explore related products

Moisture Management: Maintain consistent soil moisture; water during dry periods to support growth
Morel mushrooms thrive in environments where soil moisture is consistent, mimicking the natural conditions of their woodland habitats. Fluctuations in moisture levels can stress the mycelium, the underground network essential for fruiting, leading to poor or no harvests. Maintaining optimal soil moisture is not just about watering; it’s about creating a stable ecosystem that supports mycelial growth and, ultimately, the emergence of morels.
To achieve this, monitor soil moisture regularly using a moisture meter or by feeling the soil 2–3 inches deep. Aim for a consistently damp but not waterlogged condition, similar to a wrung-out sponge. During dry periods, water deeply once or twice a week, ensuring the moisture penetrates the root zone. Shallow watering encourages surface-level mycelium, which is more susceptible to drying out and less likely to produce mushrooms. Mulching with organic materials like straw or wood chips can help retain moisture, regulate soil temperature, and provide nutrients as they decompose.
However, overwatering is as detrimental as underwatering. Excess moisture can lead to anaerobic conditions, suffocating the mycelium and promoting competing molds or bacteria. If the soil feels soggy or puddles form after watering, reduce frequency or improve drainage by amending heavy clay soils with sand or compost. For raised beds or container setups, ensure proper drainage holes and use a well-draining soil mix.
In regions with unpredictable rainfall, consider setting up a rain barrel or irrigation system to supplement natural moisture. Automated timers can help maintain consistency, especially during peak growing seasons. Pairing moisture management with other cultural practices, such as avoiding soil compaction and maintaining a pH between 6.0 and 7.0, maximizes the chances of a successful morel harvest. By prioritizing consistent soil moisture, you create an environment where morels can flourish, turning patience and care into a rewarding culinary treasure hunt.
Mushrooms: Why They're Not Plants
You may want to see also

Harvesting Techniques: Gently twist mushrooms at the base to avoid damaging mycelium
Morel mushrooms, prized for their earthy flavor and unique honeycomb texture, require careful harvesting to ensure sustainability. One critical technique is to gently twist the mushroom at its base rather than pulling or cutting it. This method minimizes damage to the mycelium, the underground network of fungal threads that produces future mushrooms. By preserving the mycelium, you support the long-term health of the mushroom patch, allowing it to continue fruiting for years to come.
The twisting technique is straightforward but requires attention to detail. Grip the mushroom stem firmly but gently, just above the soil line. Apply a slow, steady twisting motion until the mushroom separates from the ground. Avoid yanking or tugging, as this can uproot the mycelium and disrupt its ability to regenerate. Practice this method on a few mushrooms to develop a feel for the right amount of pressure and motion. Over time, you’ll become more adept at harvesting without causing harm.
While twisting is ideal, it’s not always foolproof. Factors like soil moisture and mushroom maturity can affect how easily the stem separates. If a mushroom resists twisting, consider leaving it to mature further or using a small knife to carefully cut it at the base. However, this should be a last resort, as cutting increases the risk of damaging the mycelium. Always prioritize the twisting method whenever possible to maintain the ecosystem’s balance.
Foraging responsibly goes beyond harvesting techniques. After twisting a mushroom, take a moment to inspect the area. Avoid compacting the soil around the mycelium, as this can hinder its growth. Additionally, leave behind a few mature mushrooms to release spores, ensuring the patch’s continued proliferation. By combining the twisting technique with these mindful practices, you contribute to the preservation of morel habitats and the joy of future foraging seasons.
Mushroom Fable: A Magical Variety
You may want to see also
Frequently asked questions
To revive dried morel mushrooms, soak them in warm water for 15–20 minutes. This rehydrates them, making them plump and ready for cooking. Discard the soaking water, as it may contain grit or debris.
Once morels are overcooked and mushy, they cannot be fully restored. However, you can use them in dishes like sauces, soups, or stuffings where their texture is less critical but their flavor can still shine.
If morels are excessively dirty, gently rinse them under cold water, then pat them dry with a paper towel. Alternatively, soak them briefly in water, agitate to remove dirt, and then dry thoroughly before cooking.
























